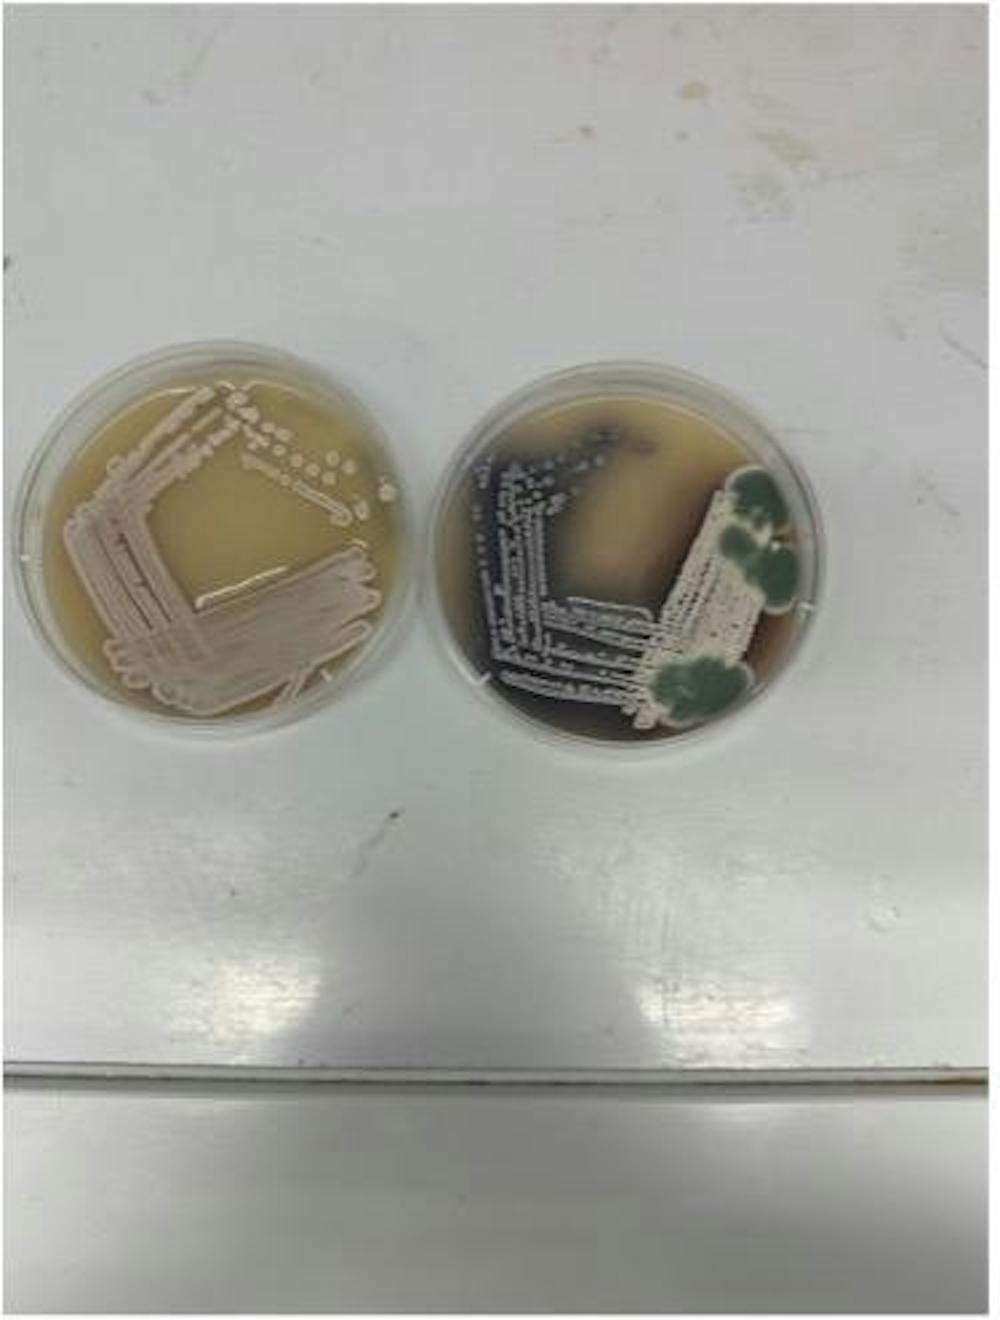

More
Tattoo Collage of students around campus
Karlee Laegel | December 3A collage of tattoos that people have around campus. Credit for the snake with flowers picture to John Rose.
christmas bad
December 3Image by <a href=" https://www.vectorportal.com" >Vectorportal.com</a>, <a class="external text" href="https://creativecommons.org/licenses/by/4.0/" >CC BY</a>
Snow outside of the Art and Comm Building
MJ Davis | December 3Otterbein saw an early snowfall for 2025
The Chirp